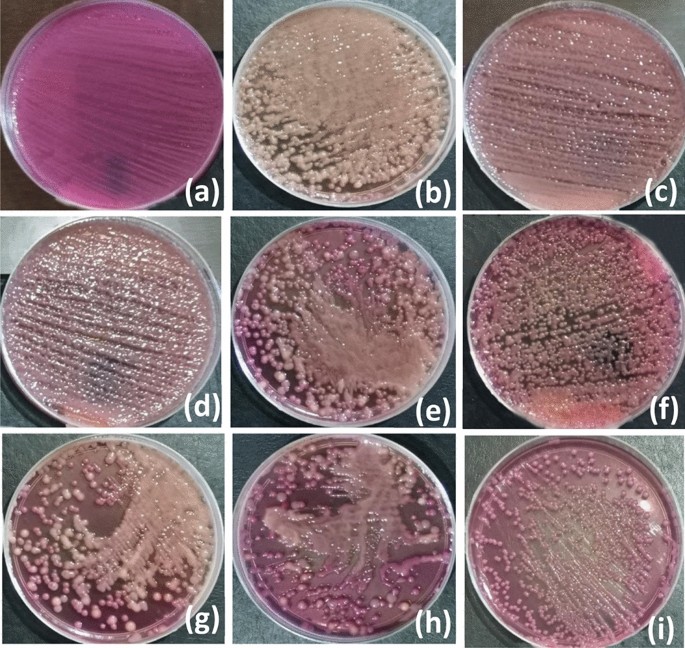
figure 9

Abstract
This paper introduces a new approach of testing piezoelectric nanofibers as antibacterial mat. In this work, both Polyvinylidene fluoride (PVDF) and PVDF embedded with thermoplastic polyurethane nanofibers are synthesized as nanofibers mat via electrospinning technique. Then, such mat is analyzed as piezoelectric material to generate electric voltage under different mechanical excitations. Furthermore, morphological and chemical characteristics have been operated to prove the existence of beta sheets piezoelectricity of the synthesized nanofibers mats. Then, the synthesized nanofibers surfaces have been cyclically stretched and exposed to bacteria specimen. It has been noticed that the generated voltage and the corresponding localized electric field positively affect the growth of bacteria and reduces the formation of K. penomenue samples bacteria colonies. In addition, the effect of both stretching frequency and pulses numbers have been studied on the bacteria count, growth kinetics, and protein leakage. Our contribution here is to introduce an innovative way of the direct impact of the generated electric field from piezoelectric nanofibers on the reduction of bacteria growth, without depending on traditional anti-bacterial nanoparticles. This work can open a new trend of the usability of piezoelectric nanofibers through masks, filters, and wound curing mats within anti-bacterial biological applications.
Similar content being viewed by others
Introduction
The groundbreaking discovery of electrospinning has attracted a lot of attention in both science and business. This mechanism can spin a wide variety of polymers into fibers with diameters ranging from several nanometers to sub-micrometers, along with the control of fibers’ characteristics like pore structure, morphology, and functionality1,2. Electrospinning depends on the electric grounding of the collecting target and the stretching electric force produced by the charges delivered to the solution from high voltage power supply. Due to the entanglements in the polymer chain within the fluid, the charged jet does not disintegrate1. A droplet at the needle's tip forms a Tylor cone when the charges reach a critical point, and a fluid jet shoots from it in the direction of the grounded collector, which has a lower potential accordingly. Since several polymers whether natural, synthetic, biodegradable, and nondegradable polymers are used to create nanofibers2 with unique and creative characteristics including polyurethanes (PU), polylactic acid (PLA), collagen, cellulose, chitosan, silk fibroin, and many more3,4,5, this technique has been used in a wide variety of industries1, including pharmaceutical, nano-catalysis, biomedicine, healthcare, protective clothing, environmental engineering, filtration6, and many others. Clay, titanium dioxide, carbon nanotubes, silica, and other inorganic nanofillers are used to create nanofiber composites with improved thermal, magnetic, electrical, fluorescent, and catalytic characteristics.
Some polymeric materials such as PVDF have a unique piezoelectric property with the ability to transform the mechanical energy to electrical energy without external inputs7,8 as a result of the electric dipole moment of PVDF monomer units due to the β-phase which is responsible for the piezoelectric behavior, and can be enhanced via electric poling and mechanical stretching9,10. This property qualifies PVDF to be a promising materials for future manufacturing of several applications, due to the high piezoelectric properties as a result of the polar crystalline structure11. The processing of PVDF in the form of nanofibers, play a crucial role in developing a flexible, lightweight, and biocompatible films for several applications such as wearable devices, wound dressing, biosensors12,13, and nano-generators14,15,16.
In a correlated track, bioengineering is one of the industries with the fastest growth rates especially when nanofibers technology started to merge inside the field17,18. The use of nanofibers in tissue engineering19 and wound dressing20 to promote cell growth and proliferation21 is increasingly crucial as nanofibrous membranes are used in medication delivery systems22 to implant drug carriers inside of patients' bodies. By changing the composition, porosity, and shape of electrospun nanofibers, the release rate of a medicine may be controlled while still maintaining an effective drug concentration at the injured area23. The electrospun nanofibers, which are excellent transporters, prevent the medication from decomposing. The systemic absorption of the medicine as well as any negative side effects can both be considerably reduced when the nanofibers are utilized as carriers for drug delivery at the specific location of the wound. The theory behind drug delivery using polymer nanofibers is that as the surface area of the drug and the matching carrier increases, so does the rate at which the drug dissolves24. The release of a pharmaceutical dosage form can be planned as delayed, immediate, fast, or modified dissolution depending on the kind of polymer carrier used for the creation of nanofibers. Several proteins, polysaccharides, growth hormones, and some anticancer medicines have all been successfully delivered via nanofibers25,26,27,28. Numerous low-molecular-weight medication solutions have been electrospun by researchers, including lipophilic pharmaceuticals like rifampin, ibuprofen, Cefazolin, Paclitaxel29, and hydrophilic drugs including mefoxin and tetracycline hydrochloride30.
Strong impact can also be achieved through nanoparticles incorporation inside nanofibers in many applications such as lithography31,32, photonics33,34,35, and antibacterial medical applications36,37. Strong inhabitation and high antibacterial effect was recorded against several bacteria when using nanoparticles such as silver (Ag)38, Zinc oxide (ZnO)39,40, and copper oxide (CuO)41, which can be used in burns, cuts, and wounds treatment with significant properties42,43 for the elimination of bacteria, viruses, fungus44,45,46 and multi-resistant bacteria47. Because there is a greater surface area exposed to the germs due to the small fiber diameter, the antibacterial impact is boosted. The nanoparticles in the composite nanofibers begin by rupturing bacterial cell walls, which has the inhibitory effect of preventing bacterial growth and ultimately leads to bacterial death48,49,50. The interaction between the bacterial cell and the oxides is facilitated by the nanoparticles' tiny size51. The method of nanoparticle penetration into bacterial cells is described by osmosis, cell-destructing enzymes, and subsequent cell death.
Along with the interest in finding alternatives to antibiotics, great attention has arisen to studying the effects of electromagnetic waves and their ability to control bacterial growth as an alternative technique rather than the use of antibiotics52,53,54. It has been proven that the electric field has a role in inactivating microorganisms under non-thermal conditions55,56,57. There are several parameters affecting the role of field interaction such as bacteria type, growing phase, and conditions of growth. Not only this but also, the field type, strength, frequency, time of application, and field proximity to exposed cells58,59,60. The metabolic process of bacterial cells possesses various intercommunication signals that acting between cells to complete the vitality process61. The application of external localized fields may cause disruption of cellular membrane charge distribution and hence lead to electrical stress on the bacterial bio-entity55,62,63,64. Even at very low energy electric fields, they have the ability to penetrate the biological systems with almost no attenuation and to modify the natural biorhythms and existing signal transduction processes in cell membranes65. The transmembrane receptors and vertebral macromolecules allocated through the cellular envelop are acting as a group of electric fields antennae that can differentiate, discern, and transform the wave energies into signals66. Consequently, the impact application of close proximity electric fields may lead to severe cellular structural changes that eventually lead to lethal effect and drive to cell lysis67.
In this work, we are introducing an innovative antibacterial impact of piezoelectric nanofibers to use the generated localized electric field from mechanical excitations, such as cyclic tension, into a direct effect on bacteria. The used nanofibers are composed of pure PVDF nanofibers and PVDF mixed with Thermoplastic polyurethane (TPU) to give more mechanical stretching capabilities. From a recent published work by the authors, the addition of TPU at certain optimum concentration can lead to enhance the piezoelectric sensitivity due to the higher mechanical stretchability that TPU can contribute68. Then, different piezoelectric analysis has been operated to show the generated electric voltage under different mechanical excitations including cyclic tension, cyclic normal force, and impulse loading. In addition, beta phase analysis using both XRD and FTIR is carried out to prove the piezoelectric performance of the synthesized nanofibers mats. Therefore, the stretched piezoelectric nanofibers are exposed to a specimen of bacteria to check the effect of generated voltage and corresponding localized electric field on the life of the bacteria colonies and its kinetic growth. Different stretching frequencies and number of stretching cycles are examined on the antibacterial performance.
Materials and methods
Materials
Polyvinylidene fluoride (PVDF) was purchased from ARKEMA (Kynar®, King of Prussia, PA, USA), Thermoplastic polyurethane (TPU) was ordered from (BASF Co., Ltd., Berlin, Germany) with 107,020 g mol−1 molecular weight and Polydispersity Index (PDI) of 1.83. Certain concentrations of the polymers were dispersed in dimethylformamide (DMF 98%) from (Sigma Aldrich, Taufkirchen, Germany).
Membrane fabrication
PVDF polymer solution of 10 wt% was prepared by adding the polymer powder into DMF. Similar concentration of TPU polymer solution was prepared by dispersing the polymer pellets into DMF, and a blended ratio was prepared with total concentration of 10% for PVDF:TPU, but with a weight ratio equals to 85:15, respectively. Knowingly that, this ratio has been chosen according to previous study performed by the same research team (68). The prepared polymer solutions were stirred overnight before the spinning process. Electrospinning process was performed by adding the prepared polymer solutions of PVDF and PVDF/TPU into plastic syringes with stainless steel needles of gauge 21. A high voltage power supply provided 30 kV (CZE1000R, Spellman, Hauppauge, NY, USA) to the syringe needle, and a constant feed rate of 1 mL/hr was fixed by NE1000 syringe pump (New Era Pump Systems, Suffolk County, NY, USA). A distance of 10 cm was adjusted between the needle and the grounded drum collector.
Morphological, Chemical and Mechanical Characterizations
Scanning Electron Microscopy through (JEOL JSM-6010LV-SEM, Tokyo, Japan) was performed to observe the surface morphology of PVDF and PVDF/TPU nanofibrous membranes with 15 kV acceleration voltage. The nanofiber membranes were fixed on a carbon tape over aluminum stubs and sputter coated with platinum. The nanofibers diameters were analyzed through Image-J software (Madison, WI, USA) and the fiber diameter distribution was detected manually at different imaging scales. The Fourier Transform Infra-Red Spectrometer (FT-IR) (Vertex 70 FT-IR, Bruker, Billerica, MA, USA) was used to calculate the β phase content in ATR mode. The nanofibers were scanned 120 times at a resolution of 5 cm−1 over a range of 4000–400 cm−1. The mechanical tensile testing was performed through Texture Analyzer CTX (AMETEK Brookfield, Middleboro, USA) by cutting the produced nanofibrous membranes into rectangular (1 × 6 cm2) and placing each sample between two cardboards frames. The thickness was measured by spring-based micrometer. Strain rate of 10 mm/min and zero initial loads were fixed. The used load cell was equal to 50 N. Each sample was tested three times and then the average stress–strain curve has been analyzed, to detect maximum tensile strength and the breaking strain where the strain where the sample was cut.
Piezoelectric Analysis
The Piezoelectric characterizations for pure PVDF and PVDF: TPU 15% were measured using various testing such as impulse, frequency, and stretching responses. The impulse response has measured using a simple setup as shown in Fig. 1. The nanofiber samples were sandwiched between two conductive materials connected with a high impedance oscilloscope (Tektronix MDO3014), using isolated wire. A different weights 20–150 g have been thrown from 1 cm height onto the nanofiber system and the output voltages have been measured using the oscilloscope.
The schematic of the impulse loading setup with different weights68.
In another test, the cyclic load has been applied on nanofiber system for measuring the frequency response using a light-weight spring built-up vertically controlled by brash-less DC motor connected with an electronic speed controller as shown in Fig. 2. The cyclic load pressed on the sandwiched nanofiber with applied range force 1–4 N, and the peak-to-peak output voltage was measured by the oscilloscope. For piezo-analysis under stretching impact, the piezoelectric stretching test is controlled by Texture Analyzer with frequency 1 Hz as shown in Fig. 3a, the sample dimensions is 1 × 4 cm2 and sandwiched between two stretchable metallic electrodes as shown in Fig. 3b. The electrodes are wired together and the output voltage is measured with the oscilloscope.
The cyclic piezoelectric schematic68.
Antibacterial Characterization
Standard strain of K. pneumoniae (ATCC 70068) was collected from Alexandria University Hospital, Egypt. It is worthwhile clarifying that the chosen bacteria strain is based on recent findings in our lab which confirmed the antibacterial effect of exposure to electromagnetic fields as a stressor co-factor against K. pneumoniae69,70.The isolates were inoculated in MacConkey agar plates at 37 °C for 24 h. For maintaining fresh subcultures, every while three colonies were added into sterilized MacConkey broth media and incubated at 37 °C for 24 h. Then after, a cultured supernatant stock inoculated in MacConkey broth by approximately 105 CFU of K. pneumonia was prepared. Four groups of bacteria samples are collected after exposure to electric pulses generated from nanofibers at three different exposure conditions and one group of bacteria sample free of exposure is considered as a control one. It is worthy to state that the nanofiber sheets were stretched mechanically in three frequency bases (0.5, 1.0, 1.5, 2.0 Hz) and every time the bacteria samples were sprayed over the sheets before stretching and collected by taking swaps after the mechanical stretches. The growth characteristics of bacteria samples were evaluated by measuring growing turbidity in broth media and plate counts in agar media. The optical density (OD) of turbid inoculated broths were monitored every 1 h by taking 1 ml from 25 ml transparent glass bottles of the supernatants under treatment in a semi-micro quartz cuvette (P.N. 035 127). The OD measurements were carried out by using a spectrophotometer (Jenway, 6405 UV/vis, Essex, UK) set at 600 nm and every 0.1 in OD reading scale is considered as 108 bacteria cells per cm371. Furthermore, the growth counts were measured by using plate counting technique to get CFU values confirming the obtained OD measurements. The growth curves between OD values and incubation times were graphed. The curves were analyzed and corresponding arbitrary rate constants were calculated according to the following formulae and graphed versus concentrations for each applied frequency72.
where N is the bacterial cell count at the time (t) and No the initial cell count. In addition, the cytotoxicity was assessed by lactate dehydrogenase (LDH), nucleic acid and protein leakage into the culture medium. The levels of LDH values, protein leakage amounts and nucleic acid percentages were obtained by methods adapted by Kim et al.73, Li et al.74, and Riss et al.75, respectively. Results were analyzed and presented as a percentage of control values and graphed relative to it.
Results and Discussion
Morphological Characterization
Figure 4 shows SEM images of the produced PVDF and PVDF/TPU (85:15) nanofibrous membranes which clarifies homogeneous and smooth surface morphology with minimized beads or agglomerations. Then, TPU was smoothly well-mixed within the PVDF solution and that mixture generally forms an excellent polymer chain entanglements with nearly no formed beads in the stage of nanofibers formation. The average fiber diameter and fiber distribution was calculated, as TPU addition increases the diameter of the nanocomposite with achieving mean fiber diameter of 173 nm and 211 nm for both pure PVDF and PVDF/TPU (85:15), respectively, proving the high compatibility and blending of the polymer solutions. The reason of the diameter’s increase is mainly coming from both reduced electrolyte property and dielectric nature of TPU. Therefore, when TPU was affiliated, less ions were formed in the blend solution with reduced charge density could be carried by the electrospinning jet and consequently less solution conductivity. That will lead to less stretching of the electrospun jet and then larger formed mean diameter of PVDF:TPU nanofibers, compared to pure PVDF76,77.
Physical Characterization
Figure 5 shows the FT-IR spectra for the produced nanofibrous membranes to study the crystalline phases for the PVDF nanofibers. Since the β-phase is the responsible for the enhancement of the piezoelectric property, increasing the β-phase content improves the piezoelectric response in the produced nanofibers. It was observed that electrospinning process has a positive impact on the piezoelectricity of the PVDF due to the high electric field effect on aligning the dipoles78. As shown in Fig. 5, the characteristic bands of PVDF appeared at 840 cm−1 corresponding to the rocking of CH2, C–C, and CF2 stretching, in addition to 1175 cm−1 for C–F and 1400 cm−1 for C–H vibrations78,79,80. Nevertheless, the main characteristic bands for TPU were observed at 3365, 2971, 1735, and 1533 cm−1, corresponding to N–H stretching, C–H, C = O, and CONH– asymmetrical bond, respectively81,82. The β-phase fraction was calculated as shown in Table 1, through the following equation:
where Aα and Aβ are the intensities of 764 cm−1 and 840 cm−1 absorbance bands, respectively. Table 1 shows that the addition of TPU to PVDF enhances the formed β-sheets concentrations inside the nanofibers. Although the concentrations of both Aα and Aβ were reduced according to the addition of TPU, the β-phase fraction was increased within PVDF: TPU sample compared to pure PVDF membrane. Accordingly, the piezoelectric response can be developed for TPU added samples compared to the pure PVDF ones, as will be shown in a later section.
Mechanical Characterization
Stress–strain curves of PVDF and PVDF/TPU nanofibrous membranes are shown in Fig. 6. Significant improvement in the mechanical properties was observed by the addition of TPU to the polymer matrix. Pure PVDF nanofibrous membrane achieved tensile strength of 2.1 MPa and breaking strain equal to 17%, while PVDF/TPU showed higher elasticity with tensile strength of 4.2 MPa and elongation at breakage of 59%. Adding TPU enhanced the mechanical properties making the composite membrane a promising candidate for different applications according to the enhanced mechanical stretchability83,84,85.
Piezoelectric Analysis
In this section, the generated peak-to-peak output voltages are detected under different applied mechanical excitations including impulse loading of free fallen masses with different weights, mechanical cyclic forces, and cyclic stretching/tension. Figure 7 shows that as the impulse weight, frequency, and the stretch increase the output voltage increase and tend to be saturated which gives us an indication to the maximum material polarization. For the force/voltage test, the output voltage curve of PVDF: TPU 15% nanofiber starts to be saturated at 0.8 V when force of 1.5 N is applied, whereas the pure PVDF nanofiber saturated at 0.6 V as shown in Fig. 7b. Now, when a fixed pressure force of 1.5 N at different cyclic frequencies is applied, the saturated curve of PVDF: TPU 15% get enhanced to 1.75 V at 2 Hz as shown in Fig. 7d. Figure 7e shows the piezoelectric sensitivity of the mat at different stretched strains. It is noticed that the results of PVDF: TPU 15% mat is quite larger than the pure PVDF mat up to ~ 8% strain limit. Beyond this limit, the PVDF: TPU mat is able to be stretchable and generate larger voltage, while the pure PVDF nanofibers reached to the breaking point.
From the previous discussion, the output peak-to-peak voltage of the blended PVDF: TPU mat is found to be larger than the pure PVDF for the impulse, cyclic, and stretching responses. In addition, the comparison between the impulse and frequency responses shows that the response of blended PVDF:TPU, according to the frequency increase is more effective than the incremented applied force as shown in both Fig. 7a,c. Also, the blended PVDF:TPU has better stretching property, which gives us an obvious improvement in the piezoelectric output voltage according to its better face-shear piezoelectricity which is related to the increased possibility of electric dipoles alignment due to the stretching nature of added TPU68,86,87.
Antibacterial Characterization
Now, it will be shown the effect of exposing gram-negative bacteria Klebsiella penomenue (k. penomenue) to piezoelectric field pulses (PEPs) generated from PVDF and PVDF-TPU nanofibers under application of mechanical stretches. The antibacterial effect of PEPs was obtained by measuring the growth kinetics over 20 h of incubation and by plate colony counts. Furthermore, bacterial cytotoxicity was investigated by measuring the percentage of protein leakage, the level of the lactate dehydrogenase enzyme (LDH), and nucleic acid changes in comparison to control samples. It is worth to note that the PEPs are generated from mechanical stresses applied over the PVDF nanofiber mats, and so, here we divided the groups of nanofiber samples based on the number of applied mechanical stretches. The applied mechanical stretches were adapted by time of application and represented as frequency “in terms of Hz” resulted from dividing different number of pulses per relevant sets of times (f = 0.5, 1, 1.5, and 2 Hz). It is worthwhile clarifying that the generation of PEPs was done by applying different numbers of mechanical stretches within certain periods at the aforementioned frequencies to check the influence of pulse numbers and stretching times as an antibacterial agent. The bacterial log reduction values for k. penomenue samples treated by PEPs generated from PVDF and PVDF-TPU nanofibers at set of frequencies are tabulated in Table 2. The obtained log reduction values showed remarkable difference of samples treated by PEPs under application of PEPs in frequency and nanofiber type dependent manner. Significantly, the maximum bacterial reduction by 4.7 log (99.99% reduction) was obtained at frequency 2.0 Hz due to PEPs generated from PVDF-TPU nanofibers. Besides that, the effect of applied mechanical stretches on PVDF-TPU nanofiber mats remarkably influenced the growth of bacteria count in a way that as many stretches were applied, or in another way the generated pulses, hence a higher bacteriostatic effect was obtained.
Furthermore, bacteria growing kinetics were studied and graphed under the application of PEPs generated from PVDF and PVDF-TPU nanofibers at set of frequencies (f = 0.5, 1, 1.5, and 2 Hz) as shown in Fig. 8. The images of k. penomenue colonies grown in MacConkey media exposed to PEPs generated from PVDF and PVDF-TPU nanofibers at set of frequencies (f = 0.5, 1, 1.5, and 2 Hz) in comparison to control one are represented in Fig. 9. It is worthy to mention here that the images were shown for presentation purpose to clarify the difference in growing density under treatment conditions; while the countable petri dishes were adopted to the streak plate method at serial dilutions. The measurement of optical density (OD) represents the density of bacteria growth in accordance to its count and could be taken to demonstrate the inhibition characteristics. In addition, the growth curves were mathematically analyzed and its corresponding arbitrary growth constants for each curve were calculated. The arbitrary constant values versus frequencies for PVDF and PVDF-TPU nanofibers were graphed as shown in Fig. 10. The characteristic growing curves in Fig. 8 illuminated normal growth phases without any abnormalities for all treated samples as compared with control ones. Also, the maximum growth depression was shown for bacteria samples treated by PEPs generated from PVDF-TPU nanofibers at 2 Hz. The arbitrary constant is an index of the growth rate and reflects the possible changes in bacterial growing kinetics as a result of treatment by PEPs. Hence, the sequential decrease in the constant values is shown in Fig. 10, which points to a higher antibacterial effect resulted from PEPs generated from PVDF-TPU nanofibers through the frequencies range (1, 1.5, and 2 Hz). The obtained ultimate growth inhibition was at frequency 2 Hz for both PVDF and PVDF-TPU nanofibers.
The petri dishes images of k. penomenue colonies cultured in MacConkey media for control samples − 0.0 Hz (a), and samples exposed to PEPs generated from PVDF at 0.5 Hz-30 s (b), 1.0 Hz-30 s (c), 1.5 Hz-20 s (d), 2.0 Hz-15 s (e) and from PVDF-TPU at 0.5 Hz-30 s (f),1.0 Hz-30 s (g), 1.5 Hz-30 s (h), 2.0 Hz-30 s (i).
To that end, the growing kinetics of bacteria exposed to PEPs, which were generated from nanofibers mats, were graphed together to compare the effect of time and the number of applied mechanical stretches as shown in Fig. 11. It is worthwhile clarifying that because of the lower elasticity of PVDF than PVDF-TPU samples, it wasn’t able to make mechanical stretches more than 30 pulses. Therefore, for PVDF samples, the frequency of 2 Hz was adapted only to 30 pulses over 15 s and for PVDF-TPU samples it was adapted to 30 and 60 pulses over 15 and 30 s respectively. The growth characteristics in Fig. 11 indicate that the inhibition due to PEPs generated from PVDF and PVDF-TPU of 30 pulses are typically similar. Moreover, the influence of pulse number on the inhibitory effect indicated a significant increase by 70% of PVDF-TPU at 60 pulses compared to 30 pulses. Therefore, an expressively exposure to localized fields generated from nanofibers showed remarkable influence on bacteria' cells vitality. The pulse number has the leverage action against bacterial bioactivity in resemblance to a frequency-dependent manner86,87. It is worth to note that live cells possess intercommunication signals between each other to functionalize their metabolic activities61. The transmembrane specialized receptors and allocated protein molecules, acting as a group of electromagnetic antennas that can differentiate, discern, and transform the wave energies into signals88. In another way, the external electromagnetic fields have the ability to penetrate the biological systems without attenuation and they have the ability to modify the natural bio-rhythm even at very low energies89. Therefore, the train of applied pulses from PEPs generated from nanofibers has influenced the existing signal transduction processes in cell membranes by 0–1 field action because of its analogy to frequency resonance action90.
The study was extended to include the intracellular protein leakage from bacterial membranes into the extracellular medium and then measured as percentage of leakage in relative to control samples. Figure 12 shows the relative change percentages of protein leakage due to exposure to PEPs generated from PVDF and PVDF-TPU nanofibers at 1.5 Hz-20 s, 2.0 Hz-15 s and 2.0 Hz-30 s. Here, the datum level of protein leakage was considered for control samples as zero level (0%). In particular, the histogram showed enhancement of bacterial protein leakage due to exposure in all examined samples. The level of leakage was maximum for samples exposed to PEPs generated from PVDF-TPU at 60 pulse train, compared to other counts of pulses. Apparently, the leakage of protein from the bacterial cytoplasm is confirming our previous findings that inhibitory effect is in pulse number dependency. One can say that the ability of PEPs to cause local field perturbation with other cellular bio-fields may lead to cellular disruptions and dislocation of cell membrane macromolecules. Such deteriorated effect on cell membrane may expedite leakage of protein from the bacterial cytoplasm into outside91. In addition, the LDH as bio-marker enzyme was studied to confirm cellular injury due to exposure to PEPs in percentages of changes relative to control samples. The reflections of loss bacterial cell membrane integrity could be monitored by LDH increase due to cell death and lysis of its inter-constituents. Figure 13 shows the relative change of LDH% due to exposure to PEPs generated from PVDF and PVDF-TPU nanofibers at 1.5 Hz-20 s, 2.0 Hz-15 s and 2.0 Hz-30 s. Significantly maximum cell injury was observed for samples exposed to PEPs generated from PVDF-TPU nanofibers at 2.0 Hz-30 s. The injury confirmed ability PEPs to cause direct effect on bacteria outer membrane. From electrical point of view, we can consider the bacterial cell as a dielectric shell shape contains biomaterials and so, direct effect of PEPs is to alter the electrical properties of the outer layer of the cell membrane92. On the bases of heterogeneous macro and micro structure of the cell membrane and the presence of ion binding protein it may be presumed that the electrical alterations in cell envelop leaded to lose normal charge distribution93,94,95 and cause changes in the ion concentration gradient across the membrane. The changes in ionic concentration gradient caused remarkable variations in the membrane potential and hence loss of membrane molecular constituents96,97.
Moreover, to check the quality of cell inner constituents; the nucleic acid percentages were measured in relative to control samples and graphed as shown in Fig. 14. The obtained data showed inconsistent and untypical sequence of exposure effect on PEPs generated from PVDF-TPU nanofibers, where the pulses of 2.0 Hz-15 s had the maximum relative change of nucleic acid up to 30%. It may be hypothesized that the irrelevant effect in nucleic acid percentages may be resulted from the different indirect responses of inside of bacteria cells to PEPs. Here the indirect effect couldn’t be engaged to charge allocation and field disruption because the energy is not sufficient to break nucleic acid molecular bonds or DNA strands. To that end, the cell vitality is based on charge surface distribution that possess cellular intercommunication signals through transmembrane receptors allocated peripherally to the cell. Explicitly, the cell membrane structure and surface charge distribution present a conformational analysis of the possible external electric field influence98. The cell membrane potential resulting from charge distribution is related to cell membrane composition and gives biological characteristics of the cell99. Membrane stability, dynamicity and ionic uptake are dependent on the charged macromolecular head groups as key elements in modulating channels functionalized in the cell metabolic activity100,101. Different field perturbations are resulted from interaction of localized piezoelectric fields with charged macromolecular heads due to differences in their charge amount and bond length. The induced electric moments across membrane bilayer have reoriented and dislocated peripheral membrane macromolecules that caused intracellular metabolism to cease to exist and hence cell death.
Conclusions
In this work, we innovatively investigated the impact of piezoelectric electrospun nanofibers and its corresponding generated voltage on the reduction of bacteria growth. This paper introduced the fabrication of both piezoelectric PVDF and PVDF: TPU nanofibers mats via electrospinning process. The piezoelectric analysis of both mats, which contain beta-sheet concentrations up to 80%, shows the generation of voltages up to 1 V under stretching strain of more than 15% on cyclic basis. Furthermore, TPU enhanced the piezoelectric response, compared to pure PVDF, under different applied mechanical excitations according to a possible better dipoles’ alignment inside the nanofibers within the added stretchable TPU element. Then, we have used both studied nanofibers to check the antibacterial impact due to cyclic stretched piezoelectricity. The experimental results show the reduction of the formed k. penomenue bacteria colonies due to the applied cyclic stretching, and the corresponding generated voltage of both studied nanocomposite mats. In addition, the cyclic piezoelectric performance shows a slower kinetic growth of the bacteria due to the generated electric voltage, and corresponding localized electric field exposed to bacteria. Generally, PVDF:TPU nanofibers show a slower kinetic growth of bacteria up to half the similar rate of pure PVDF nanofibers according to piezoelectric field pulses (PEPs) with a frequency up to 2 Hz. In addition, PVDF:TPU shows a relative change in the nucleic acid more than 30% and relative leakage of proteins close to 200%. In summary, The piezoelectric mechanism from both PVDF and enhanced-stretchable PVDF: TPU electrospun nanofibers positively acts as an effective anti-bacterial mats. This work is promising in applying the piezoelectricity characteristics in microbiological field within masks, filters, and wound curing applications, without depending on the traditional direct contact mechanism of anti-bacterial nanoparticles.
Data availability
The datasets generated and/or analyzed during the current study are not publicly available due possible patent application, but are available from the corresponding author on reasonable request.
References
Ramakrishna, S. An Introduction to Electrospinning and Nanofibers (World Scientific, 2005).
Greiner, A. & Wendorff, J. H. Electrospinning: A fascinating method for the preparation of ultrathin fibers. Angewandte Chemie Int. Ed. 46(30), 5670–703 (2007).
Quoc Pham, L., Uspenskaya, M. V., Olekhnovich, R. O. & Olvera Bernal, R. A. A review on electrospun PVC nanofibers: Fabrication, properties, and application. Fibers 9(2), 12 (2021).
Gómez-Pachón, E. Y., Vera-Graziano, R., & Montiel Campos, R. Structure of poly (lactic-acid) PLA nanofibers scaffolds prepared by electrospinning. In IOP Conference Series: Materials Science and Engineering (IOP Publishing, 2014)
Hu, J., Wei, J., Liu, W. & Chen, Y. Preparation and characterization of electrospun PLGA/gelatin nanofibers as a drug delivery system by emulsion electrospinning. J. Biomater. Sci. Polym. Ed. 24(8), 972–85 (2013).
Suthar, A. & Chase, G. The chemical engineer. Nanofibres Filter Media 726, 26–28 (2001).
Shivashankar, P. & Gopalakrishnan, S. Review on the use of piezoelectric materials for active vibration, noise, and flow control. Smart Mater. Struct. 29(5), 053001 (2020).
Rincón-Quintero, A. D., Sandoval-Rodriguez, C. L., Zanabria-Ortigoza, N. D., Cárdenas-Arias, C. G., Ascanio-Villabona, J. G., & Durán-Sarmiento, M. A. Generation and capture of electric energy using piezoelectric materials: A review. In IOP Conference Series: Materials Science and Engineering (IOP Publishing, 2021)
Davide Fabiani, Filippo Grolli, Marco Speranza, Simone Vincenzo Suraci, Tommaso Maria Brugo, Andrea Zucchelli, and Emanuele Maccaferri. Piezoelectric nanofibers for integration in multifunctional materials. in 2018 IEEE Conference on Electrical Insulation and Dielectric Phenomena (CEIDP). 2018. IEEE.
Gomes, J., Nunes, J. S., Sencadas, V. & Lanceros-Méndez, S. Influence of the β-phase content and degree of crystallinity on the piezo-and ferroelectric properties of poly (vinylidene fluoride). Smart Mater. Struct. 19(6), 065010 (2010).
Kawai, H. The piezoelectricity of poly (vinylidene fluoride). Jpn. J. Appl. Phys. 8(7), 975 (1969).
Shehata, N. et al. Acoustic energy harvesting and sensing via electrospun PVDF nanofiber membrane. Sensors 20(11), 3111 (2020).
Zhou, H. et al. Stretchable piezoelectric energy harvesters and self-powered sensors for wearable and implantable devices. Biosens. Bioelectron. 168, 112569 (2020).
Sahoo, S., Walke, P., Nayak, S. K., Rout, C. S. & Late, D. J. Recent developments in self-powered smart chemical sensors for wearable electronics. Nano Res. 14, 1–21 (2021).
Wang, F. et al. High performance piezoelectric nanogenerator with silver nanowires embedded in polymer matrix for mechanical energy harvesting. Ceram. Int. 47(24), 35096–104 (2021).
Rana, M. M. et al. Porosity modulated high-performance piezoelectric nanogenerator based on organic/inorganic nanomaterials for self-powered structural health monitoring. ACS Appl. Mater. Interfaces 12(42), 47503–47512 (2020).
Huang, Z. M., Zhang, Y. Z., Kotaki, M. & Ramakrishna, S. A review on polymer nanofibers by electrospinning and their applications in nanocomposites. Compos. Sci. Technol. 63(15), 2223–53 (2003).
Laurencin, C. T., Ambrosio, A. M., Borden, M. D. & Cooper, J. A. Jr. Tissue engineering: orthopedic applications. Annu. Rev. Biomed. Eng. 1(1), 19–46 (1999).
Agarwal, S., Wendorff, J. H. & Greiner, A. Use of electrospinning technique for biomedical applications. Polymer 49(26), 5603–21 (2008).
Chen, J. P., Chang, G. Y. & Chen, J. K. Electrospun collagen/chitosan nanofibrous membrane as wound dressing. Colloids Surf. A Physicochem. Eng. Aspects 313, 183–8 (2008).
Sabbatier, G., Abadie, P., Dieval, F., Durand, B. & Laroche, G. Evaluation of an air spinning process to produce tailored biosynthetic nanofibre scaffolds. Mater. Sci. Eng. C 35, 347–53 (2014).
Souza, M. A., Sakamoto, K. Y. & Mattoso, L. H. Release of the diclofenac sodium by nanofibers of poly (3-hydroxybutyrate-co-3-hydroxyvalerate) obtained from electrospinning and solution blow spinning. J. Nanomater. 66, 2014 (2014).
Kaur, M., Garg, T., Rath, G. & Goyal, A. Current nanotechnological strategies for effective delivery of bioactive drug molecules in the treatment of tuberculosis. Crit. Rev.™ Therap. Drug Carrier Syst. 31(1), 66 (2014).
Goyal, G. et al. Development and characterization of niosomal gel for topical delivery of benzoyl peroxide. Drug Deliv. 22(8), 1027–42 (2015).
Casper, C. L., Yamaguchi, N., Kiick, K. L. & Rabolt, J. F. Functionalizing electrospun fibers with biologically relevant macromolecules. Biomacromolecules 6(4), 1998–2007 (2005).
Zeng, J. et al. Poly (vinyl alcohol) nanofibers by electrospinning as a protein delivery system and the retardation of enzyme release by additional polymer coatings. Biomacromolecules 6(3), 1484–8 (2005).
Metwally, M., Cheong, Y. & Li, T. C. A review of techniques for adhesion prevention after gynaecological surgery. Curr. Opin. Obstetr. Gynecol. 20(4), 345–52 (2008).
Luong-Van, E. et al. Controlled release of heparin from poly (ε-caprolactone) electrospun fibers. Biomaterials 27(9), 2042–50 (2006).
Jiang, H., Fang, D., Hsiao, B., Chu, B. & Chen, W. Preparation and characterization of ibuprofen-loaded poly (lactide-co-glycolide)/poly (ethylene glycol)-g-chitosan electrospun membranes. J. Biomater. Sci. Polym. Ed. 15(3), 279–96 (2004).
Kenawy, E. R. et al. Release of tetracycline hydrochloride from electrospun poly (ethylene-co-vinylacetate), poly (lactic acid), and a blend. J Control. Release 81(1–2), 57–64 (2002).
Xia, Y., Rogers, J. A., Paul, K. E. & Whitesides, G. M. Unconventional methods for fabricating and patterning nanostructures. Chem. Rev. 99(7), 1823–48 (1999).
Shipway, A. N., Lahav, M. & Willner, I. Nanostructured gold colloid electrodes. Adv. Mater. 12(13), 993–8 (2000).
Wang, Y. & Toshima, N. Preparation of Pd−Pt bimetallic colloids with controllable core/shell structures. J. Phys. Chem. B 101(27), 5301–6 (1997).
Lin, J. C. & Wang, C. Y. Effects of surfactant treatment of silver powder on the rheology of its thick-film paste. Mater. Chem. Phys. 45(2), 136–44 (1996).
Gould, I. R., Lenhard, J. R., Muenter, A. A., Godleski, S. A. & Farid, S. Two-electron sensitization: A new concept for silver halide photography. J. Am. Chem. Soc. 122(48), 11934–43 (2000).
Kim, J. S. et al. Antimicrobial effects of silver nanoparticles. Nanomed. Nanotechnol. Biol. Med. 3(1), 95–101 (2007).
Damm, C., Münstedt, H. & Rösch, A. The antimicrobial efficacy of polyamide 6/silver-nano-and microcomposites. Mater. Chem. Phys. 108(1), 61–6 (2008).
Dowling, D. P., Donnelly, K., McConnell, M. L., Eloy, R. & Arnaud, M. N. Deposition of anti-bacterial silver coatings on polymeric substrates. Thin Solid Films 398, 602–6 (2001).
Sirelkhatim, A. et al. Review on zinc oxide nanoparticles: antibacterial activity and toxicity mechanism. Nano-micro Lett. 7(3), 219–42 (2015).
Colon, G., Ward, B. C. & Webster, T. J. Increased osteoblast and decreased Staphylococcus epidermidis functions on nanophase ZnO and TiO2. J. Biomed. Mater. Res. A 78(3), 595–604 (2006).
Stafford, S. L. et al. Metal ions in macrophage antimicrobial pathways: emerging roles for zinc and copper. Biosci. Rep. 33(4), 66 (2013).
Abdel-Halim, E. S., El-Rafie, M. H. & Al-Deyab, S. S. Polyacrylamide/guar gum graft copolymer for preparation of silver nanoparticles. Carbohyd. Polym. 85(3), 692–7 (2011).
Ifuku, S., Tsuji, M., Morimoto, M., Saimoto, H. & Yano, H. Synthesis of silver nanoparticles templated by TEMPO-mediated oxidized bacterial cellulose nanofibers. Biomacromolecules 10(9), 2714–7 (2009).
Gurunathan, S. et al. Reduced graphene oxide–silver nanoparticle nanocomposite: a potential anticancer nanotherapy. Int. J. Nanomed. 10, 6257 (2015).
Kathiravan, V., Ravi, S. & Ashokkumar, S. Synthesis of silver nanoparticles from Melia dubia leaf extract and their in vitro anticancer activity. Spectrochimica Acta Part A Mol. Biomol. Spectrosc. 130, 116–21 (2014).
Vimala, K., Sivudu, K. S., Mohan, Y. M., Sreedhar, B. & Raju, K. M. Controlled silver nanoparticles synthesis in semi-hydrogel networks of poly (acrylamide) and carbohydrates: A rational methodology for antibacterial application. Carbohyd. Polym. 75(3), 463–71 (2009).
Atiyeh, B. S., Costagliola, M., Hayek, S. N. & Dibo, S. A. Effect of silver on burn wound infection control and healing: review of the literature. Burns 33(2), 139–48 (2007).
Abdelgawad, A. M., Hudson, S. M. & Rojas, O. J. Antimicrobial wound dressing nanofiber mats from multicomponent (chitosan/silver-NPs/polyvinyl alcohol) systems. Carbohyd. Polym. 100, 166–78 (2014).
El-Naggar, M. E., Shaheen, T. I., Fouda, M. M. & Hebeish, A. A. Eco-friendly microwave-assisted green and rapid synthesis of well-stabilized gold and core–shell silver–gold nanoparticles. Carbohyd. Polym. 136, 1128–36 (2016).
Hebbalalu, D., Lalley, J., Nadagouda, M. N. & Varma, R. S. Greener techniques for the synthesis of silver nanoparticles using plant extracts, enzymes, bacteria, biodegradable polymers, and microwaves. ACS Sustain. Chem. Eng. 1(7), 703–12 (2013).
Stanić, V., & Tanasković, S. B. Antibacterial activity of metal oxide nanoparticles. In Nanotoxicity 241–274 (Elsevier, 2020).
Zhou, H. et al. Pulse electromagnetic fields enhance extracellular electron transfer in magnetic bioelectrochemical systems. Biotechnol. Biofuels 10(1), 1 (2017).
Nawrotek, P., Fijałkowski, K., Struk, M., Kordas, M. & Rakoczy, R. Effects of 50 Hz rotating magnetic field on the viability of Escherichia coli and Staphylococcus aureus. Electromagn. Biol. Med. 33(1), 29–34 (2014).
Bayır, E., Bilgi, E., Şendemir-Ürkmez, A. & Hameş-Kocabaş, E. E. The effects of different intensities, frequencies and exposure times of extremely low-frequency electromagnetic fields on the growth of Staphylococcus aureus and Escherichia coli O157: H7. Electromagn. Biol. Med. 34(1), 14–8 (2015).
Ohanyan, V., Sarkisyan, A., Tadevosyan, A. & Trchounian, A. The effect of low-intensity coherent extremely high frequency electromagnetic radiation on growth parameters for Enterococcus hirae bacteria. Biophysics 53(5), 406–8 (2008).
Bilalis, D., Katsenios, N., Efthimiadou, A., Efthimiadis, P. & Karkanis, A. Pulsed electromagnetic fields effect in oregano rooting and vegetative propagation: A potential new organic method. Acta Agric. Scand. Sect. B Soil Plant Sci. 62(1), 94–9 (2012).
Giorgi, G. et al. Assessing the combined effect of extremely low-frequency magnetic field exposure and oxidative stress on LINE-1 promoter methylation in human neural cells. Radiat. Environ. Biophys. 56(2), 193–200 (2017).
Masood, S. Effect of weak magnetic field on bacterial growth. Biophys. Rev. Lett. 12(04), 177–86 (2017).
Tessaro, L. W., Murugan, N. J. & Persinger, M. A. Bacterial growth rates are influenced by cellular characteristics of individual species when immersed in electromagnetic fields. Microbiol. Res. 172, 26–33 (2015).
Saleem, I., Masood, S., Smith, D. & Chu, W. K. Adhesion of gram-negative rod-shaped bacteria on 1D nano-ripple glass pattern in weak magnetic fields. MicrobiologyOpen 8(2), e00640 (2019).
Luben, R. A. Effects of low-energy electromagnetic fields (pulsed and DC) on membrane signal transduction processes in biological systems. Health Phys.s 61(1), 15–28 (1991).
Chow, K. C. & Tung, W. L. Magnetic field exposure stimulates transposition through the induction of DnaK/J synthesis. Biochem. Biophys. Res.Commun. 270(3), 745–8 (2000).
Del Re, B. et al. Extremely low frequency magnetic fields affect transposition activity in Escherichia coli. Radiat. Environ. Biophys. 42(2), 113–8 (2003).
Fijałkowski, K., Nawrotek, P., Struk, M., Kordas, M. & Rakoczy, R. Effects of rotating magnetic field exposure on the functional parameters of different species of bacteria. Electromagn. Biol. Med. 34(1), 48–55 (2015).
Valberg, P. A., Kavet, R. & Rafferty, C. N. Can low-level 50/60 Hz electric and magnetic fields cause biological effects?. Radiat. Res. 148(1), 2–1 (1997).
Mihai, C. T., Rotinberg, P., Brinza, F. & Vochita, G. Extremely low-frequency electromagnetic fields cause DNA strand breaks in normal cells. J. Environ. Health Sci. Eng. 12(1), 1–7 (2014).
Rakoczy, R., Konopacki, M. & Fijałkowski, K. The influence of a ferrofluid in the presence of an external rotating magnetic field on the growth rate and cell metabolic activity of a wine yeast strain. Biochem. Eng. J. 109, 43–50 (2016).
Shehata, N. et al. Stretchable nanofibers of polyvinylidenefluoride (PVDF)/thermoplastic polyurethane (TPU) nanocomposite to support piezoelectric response via mechanical elasticity. Sci. Rep. 12(1), 1–1 (2022).
El-Kaliuoby, M. I., El-Khatib, A. M. & Khalil, A. M. Does engineering of nanoshapes have antibacterial synergy with magnetic signal exposure?. Surf. Innov. 7(5), 260–7 (2019).
El-Khatib, A. M., Khalil, A. M., Elkaliuoby, M. I. & Elkhatib, M. The combined effects of multisized silver nanoparticles and pulsed magnetic field on K. pneumoniae. Bioinspir. Biomimet. Nanobiomater. 8(2), 154–160 (2019).
Sondi, I. & Salopek-Sondi, B. Silver nanoparticles as antimicrobial agent: a case study on E. coli as a model for Gram-negative bacteria. J. Colloid Interface Sci. 275(1), 177–82 (2004).
Tiwari, D. K., Behari, J. & Sen, P. Time and dose-dependent antimicrobial potential of Ag nanoparticles synthesized by top-down approach. Curr. Sci. 10, 647–55 (2008).
Kim, S. H., Lee, H. S., Ryu, D. S., Choi, S. J. & Lee, D. S. Antibacterial activity of silver-nanoparticles against Staphylococcus aureus and Escherichia coli. Microbiol. Biotechnol. Lett. 39(1), 77–85 (2011).
Li, W. R. et al. Antibacterial activity and mechanism of silver nanoparticles on Escherichia coli. Appl. Microbiol. Biotechnol. 85(4), 1115–22 (2010).
Riss, T., Niles, A., Moravec, R., Karassina, N. & Vidugiriene, J. Cytotoxicity assays: in vitro methods to measure dead cells. Assay Guid. Manual 66, 6 (2019).
Chen, R., Qiu, L., Ke, Q., He, C. & Mo, X. Electrospinning thermoplastic polyurethane-contained collagen nanofibers for tissue engineering applications. J. Biomater. Sci. Polym. Ed. 20(11), 1513–1536 (2009).
Maleki, S., Shamloo, A. & Kalantarnia, F. Tubular TPU/SF nanofibers covered with chitosan-based hydrogels as small-diameter vascular grafts with enhanced mechanical properties. Sci. Rep. 12, 6179 (2022).
Sengupta, D. et al. Characterization of single polyvinylidene fluoride (PVDF) nanofiber for flow sensing applications. AIP Adv. 7(10), 105205 (2017).
Mahato, P. K., Seal, A., Garain, S. E. N. S. & Sen, S. Effect of fabrication technique on the crystalline phase and electrical properties of PVDF films. Mater. Sci. Pol. 33(1), 157–162 (2015).
Kaspar, P. et al. Characterization of Polyvinylidene fluoride (PVDF) electrospun fibers doped by carbon flakes. Polymers 12(12), 2766 (2020).
Gergeroglu, H. & Huseyin, A. V. Functional composite nanofibers derived from natural extract of Satureja hortensis. Anadolu Univ. J. Sci. Technol. A Appl. Sci. Eng. 18(5), 908–18 (2017).
Shaker, A., Hassanin, A. H., Shaalan, N. M., Hassan, M. A. & Abd El-Moneim, A. Micropatterned flexible strain gauge sensor based on wet electrospun polyurethane/PEDOT: PSS nanofibers. Smart Mater. Struct. 28(7), 075029 (2019).
Guo, H.-F. et al. Piezoelectric PU/PVDF electrospun scaffolds for wound healing applications. Colloids Surf. B 96, 29–36 (2012).
Chen, R. et al. Transparent thermoplastic polyurethane air filters for efficient electrostatic capture of particulate matter pollutants. Nanotechnology 30(1), 015703 (2018).
Tang, J., Wu, Y., Ma, S., Yan, T. & Pan, Z. Flexible strain sensor based on CNT/TPU composite nanofiber yarn for smart sports bandage. Compos B Eng. 66, 109605 (2022).
Dai, Z. et al. Thermoplastic polyurethane elastomer induced shear piezoelectric coefficient enhancement in bismuth sodium titanate–PVDF composite films. J. Appl. Polym. Sci. 138(6), 49818 (2021).
Tirella, A., Mattei, G. & Ahluwalia, A. R. Strain rate viscoelastic analysis of soft and highly hydrated biomaterials. J. Biomed. Mater. Res. A 102(10), 3352–60 (2014).
Gobba, F., Malagoli, D. & Ottaviani, E. Effects of 50 Hz magnetic fields on fMLP-induced shape changes in invertebrate immunocytes: The role of calcium ion channels. Bioelectromagnetics 24(4), 277–82 (2003).
Belyaev, I. Y., Shcheglov, V. S., Alipov, Y. D. & Polunin, V. A. Resonance effect of millimeter waves in the power range from 10–19 to 3 × 10–3 W/cm2 on Escherichia coli cells at different concentrations. Bioelectromagnetics 17(4), 312–21 (1996).
El-Kaliuoby, M. I., Khalil, A. M. & El-Khatib, A. M. Alterations of bacterial dielectric characteristics due to pulsed magnetic field exposure. Bioinspir. Biomimet. Nanobiomater. 9(2), 103–11 (2020).
Gurunathan, S., Han, J. W., Kwon, D. N. & Kim, J. H. Enhanced antibacterial and anti-biofilm activities of silver nanoparticles against Gram-negative and Gram-positive bacteria. Nanoscale Res. Lett. 9(1), 1–7 (2014).
Asami, K. Low-frequency dielectric dispersion of bacterial cell suspensions. Colloids Surf. B Biointerfaces 119, 1–5 (2014).
Belyaev, I. Y. & Alipov, E. D. Frequency-dependent effects of ELF magnetic field on chromatin conformation in Escherichia coli cells and human lymphocytes. Biochimica et Biophysica Acta BBA General Subj. 1526(3), 269–76 (2001).
Lednev, V. V. Possible mechanism for the influence of weak magnetic fields on biological systems. Bioelectromagnetics 12(2), 71–5 (1991).
Blanchard, J. P. & Blackman, C. F. Clarification and application of an ion parametric resonance model for magnetic field interactions with biological systems. Bioelectromagnetics 15(3), 217–38 (1994).
Prodan, E., Prodan, C. & Miller, J. H. Jr. The dielectric response of spherical live cells in suspension: an analytic solution. Biophys. J. 95(9), 4174–82 (2008).
Di Biasio, A., Ambrosone, L. & Cametti, C. The dielectric behavior of nonspherical biological cell suspensions: an analytic approach. Biophys. J. 99(1), 163–74 (2010).
Nishino, M. et al. Measurement and visualization of cell membrane surface charge in fixed cultured cells related with cell morphology. PLoS ONE 15(7), e0236373 (2020).
Pöyry, S. & Vattulainen, I. Role of charged lipids in membrane structures—Insight given by simulations. Biochimica et Biophysica Acta BBA Biomembr. 1858(10), 2322–2333 (2016).
Purves, D. & Williams, S. M. Neuroscience 2nd edn, 681 (Sinauer Associates, 2001).
Róg, T. et al. Interdigitation of long-chain sphingomyelin induces coupling of membrane leaflets in a cholesterol dependent manner. Biochim. Biophys. Acta 2015, 281–288 (1858).
Funding
Open access funding provided by The Science, Technology & Innovation Funding Authority (STDF) in cooperation with The Egyptian Knowledge Bank (EKB).
Author information
Authors and Affiliations
Contributions
A.H and N.S initiate the idea and put the plan for the DOE suprvise the expermintal work. A.K and M.E have carried out the methodology especially the microbiological part. N.O and M.G did all the physical, mechanical and piezoelectric measurements. I.K and A.E has supervise all piezoelectric measurement and results. N.O and M.G prepared all the figures for the physical, mechanical and piezoelectric measurements wrote the first draft of the main manuscript. A.K. M.E, and A.E prepared all the figures for the microbiological part. All authors reviewed the manuscript.
Corresponding author
Ethics declarations
Competing interests
The authors declare no competing interests.
Additional information
Publisher's note
Springer Nature remains neutral with regard to jurisdictional claims in published maps and institutional affiliations.
Rights and permissions
Open Access This article is licensed under a Creative Commons Attribution 4.0 International License, which permits use, sharing, adaptation, distribution and reproduction in any medium or format, as long as you give appropriate credit to the original author(s) and the source, provide a link to the Creative Commons licence, and indicate if changes were made. The images or other third party material in this article are included in the article's Creative Commons licence, unless indicated otherwise in a credit line to the material. If material is not included in the article's Creative Commons licence and your intended use is not permitted by statutory regulation or exceeds the permitted use, you will need to obtain permission directly from the copyright holder. To view a copy of this licence, visit http://creativecommons.org/licenses/by/4.0/.
About this article
Cite this article
Khalil, A.M., Hassanin, A.H., El-kaliuoby, M.I. et al. Innovative antibacterial electrospun nanofibers mats depending on piezoelectric generation. Sci Rep 12, 21788 (2022). https://doi.org/10.1038/s41598-022-25212-3
Received:
Accepted:
Published:
Version of record:
DOI: https://doi.org/10.1038/s41598-022-25212-3